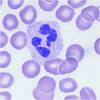
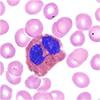
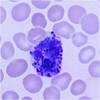
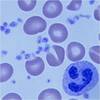

Semester Review Flashcards
(181 cards)
Confidentiality
All information about a patient is protected
Phlebotomy
The practice of drawing blood; to cut into a vein
Accreditation
Official approval of a program from a professional organization
Certification
Verification that an individual has demonstrated proficiency in a particular area of practice
Licensure
A document permit issued by a government agency that grants the bearer permission to provide a particular service or procedure
ASCP
American Society for Clinical Pathologist
NAACLS
National Accrediting Agency for Clinical Laboratory Sciences
ASPT
American Society for Phlebotomy Technicians
AMT
American Medical Technologist
List the regular duties of a phlebotomist
Obtain blood samples, adhere to safety regulations, keep accurate records
What is the first step you perform in a routine blood collection?
Identify the patient
What does the Health Insurance Portability and Accountability Act of 1996 (HIPPA) regulate?
Privacy of medical information
CCU
Coronary Care Unit or Cardiac Care Unit
CLIA
Clinical Lab Improvement Act of 1988
MT
Medical Technologist
RN
Registered Nurse
GTT
Glucose Tolerance Test
RBC
Red Blood Cell
SST
Serum Separator Tube
HMO
Health Maintenance Organization
JCHAO
Joint Commission on Accreditation of Healthcare Organizations
Hemolyzed
Breakage of red blood cells and blood Blood serum has a pink tinge
Icteric
Increase in the amount of bacteria in the serum Blood is dark yellow
Lipemic
Caused by recent ingestion of lipids or fats Blood is milky white and cloudy